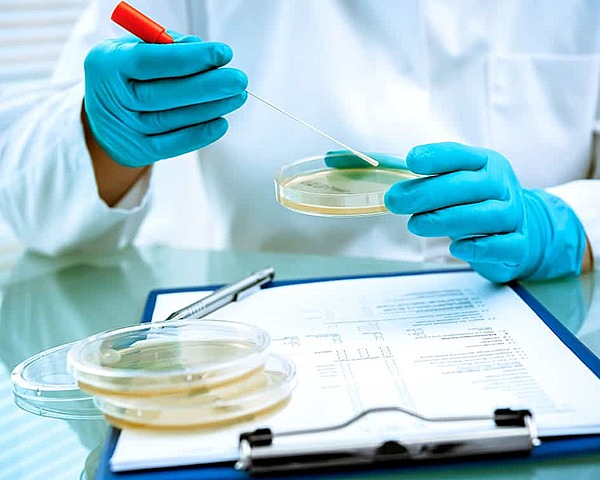
El conocimiento microbiológico actual

-
Francis Bacón plantea la hipótesis de las criaturas invisibles y que estas causaban enfermedades.
-
Fracastorius en 1546 aplica el mismo concepto de transmisibilidad a la sífilis.
-
Se produjo cuando Anton Van Leeuwenhoek inventó el primer microscopio y describe lo que el llamó “animalículos” y describe además tres presentaciones morfológicas de las bacterias: bacilos, cocos, y espirilos
-
se produce en la mitad del siglo XIX, de la mano de Luis Pasteur, con sus estudios sobre la fermentación y de Robert Koch que establece los fundamentos de la infectología. A partir de aquí no quedaron dudas que las bacterias eran agentes causales de enfermedad transmisible en el hombre, se comprendió la etiología de muchas enfermedades infecciosas y los microorganismos causales fueron identificados
-
Sucedieron una serie de acontecimientos que marcaron a este período como la época de oro de la Microbiología. Se desarrollaron métodos que permitieron el cultivo de bacterias y su identificación fenotípica.
-
-
El descubrimiento de la penicilina en 1929 por Alexander Fleming y el de las sulfonamidas en 1935 por Domagk. Lo cual fue un gran golpe para las enfermedades infecciosas.
-
Desde entonces y hasta nuestros días se extiende la segunda edad de oro de la Microbiología Médica, en la que aunque se ha podido controlar algunas de las enfermedades infecciosas que más daño han causado a la humanidad, se han descubierto nuevos patógenos como el HIV. Las bacterias han desarrollado resistencia a los antibióticos, lo que representa un gran desafío a los microbiólogo.
-
Desde la década del 50 se produjeron grandes avances en el conocimiento de los microorganismos, la microscopía electrónica permitió dilucidar la ultraestructura de los hongos, las bacterias, los protozoos y los virus. Se avanzó en la comprensión de los procesos celulares y moleculares que les permiten a los microorganismos causar enfermedad.
-
En la década de los 60 se abrió una nueva fase en la era de los antibióticos al obtenerse compuestos semisintéticos por modificación química de antibióticos naturales, paliándose los problemas de resistencia bacteriana a drogas que habían empezado a aparecer, disminuyéndose en muchos casos los efectos secundarios, y ampliándose el espectro de acción.
-
Actualmente, el conocimiento microbiológico se ha especializado tanto que lo encontramos dividido en distintas ramas:La microbiología médica, la inmunología, la microbiología ecológica, la microbiología agrícola y la biotecnología. Utilice de referencia para todo:
https://www.saberdeciencias.com/apuntes-de-microbiologia/140-microbiologia-breve-historia
Looking for a timeline maker?
Create timelines for projects, roadmaps, history, lessons, legal cases, and stories with Timetoast. Timetoast is a timeline maker for work, school, research, and stories.